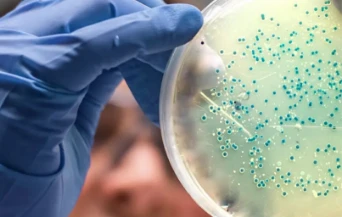
close up of an experiment
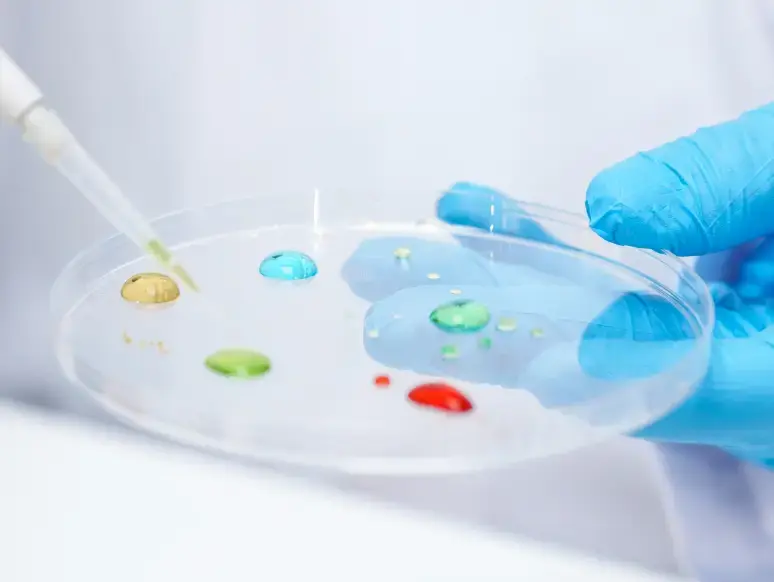

ELISpot Assay Services
Advanced ELISpot solutions for immune monitoring and research
ELISpot Assay
Services
At Synexa Life Sciences, our ELISpot (Enzyme-Linked ImmunoSpot) assay services enable precise detection and quantification of antigen-specific immune responses at the single-cell level. This highly sensitive assay measures the secretion of cytokines, antibodies, or other immune markers, providing valuable insights into immune cell activity and function.
ELISpot assays are essential for assessing immune responses in various disease settings, making them a powerful tool for immune monitoring and research.

Therapeutic Applications

Vaccine Development
Evaluate immune responses post-vaccination by identifying cytokine-secreting T-cells and B-cells, providing critical insights into vaccine efficacy.

Immunotherapy Monitoring
Track patient immune responses during immunotherapy treatments by detecting changes in cellular immune activity, offering valuable data on therapeutic effectiveness.

Infectious Disease Trials
Cell & Gene Therapy
Autoimmune Disease Trials
Why choose Synexa’s ELISpot Assays?
High Sensitivity
Accurately detect immune responses, even at low frequencies, providing crucial insights into T-cell and B-cell activity, essential for evaluating patient responses.
Custom Assay Development
Tailored assay solutions specifically designed to meet the objectives of your clinical trial, ensuring relevant and reliable data.
GCLP-Compliant
Our laboratory services strictly adhere to Good Clinical Laboratory Practice (GCLP) standards, producing high-quality data suitable for regulatory submissions and compliance in clinical trial settings.
Expert Scientific Team
Extensive expertise in developing and executing ELISpot assays across therapeutic areas such as oncology, infectious diseases, immunology, and gene therapy, ensuring robust support throughout your trial.
End-to-end Support
Comprehensive project management from assay design to data analysis and interpretation, providing a seamless experience from start to finish during clinical trials.
FAQ
Does Synexa offer custom developed ELISpot and FluoroSpot assays?
Yes, Synexa provides custom assay development and validation, ensuring alignment with trial objectives.
Why use ELISpot for immune monitoring?
ELISpot is highly sensitive and quantifies individual cytokine‑secreting cells, enabling detection of low‑frequency antigen‑specific responses.
What cytokines or analytes can Synexa measure?
Commonly IFN‑γ, IL‑2, TNF‑α, and others (e.g., IL‑17, granzyme B), depending on project needs and available reagents.
What regulatory or industry compliance standards does Synexa's ELISpot and FluoroSpot assays meet?
ELISpot and FluoroSpot assays are available in our GCLP and GLP compliant facilities. Assay validation follows the most recent published recommendations of the Global CRO Council in Bioanalysis (GCC). This ensures data quality and integrity for both clinical trial endpoints and preclinical regulatory submissions.
Can you integrate ELISpot and FluoroSpot data with other omics or functional readouts?
ELISpot and FluoroSpot outputs can be integrated into broader bioanalytical strategies, enabling combined interpretation with genomics, proteomics and soluble biomarker platforms (e.g., MSD, Olink). For cellular functional immunophenotyping, complementary flow cytometry assays are available, providing a multi-dimensional readout of immune cell function and phenotype.
Improving the quality of human health
Contact us
Discuss biomarker and bioanalytical solutions to accelerate your therapeutic pipeline
